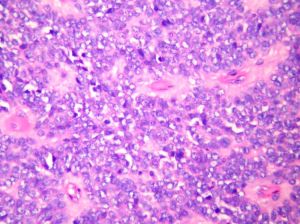
抗Sm抗體 抗Sm抗體

適應證
進行抗Sm抗體檢測的指征有:發熱、發作性對稱性關節痛,腫脹、肌痛和肌無力及四肢皮疹與腎臟病變等系統性紅斑狼瘡症狀。
臨床意義
抗Sm抗體對系統性紅斑狼瘡有高度特異性,且不論是否處於紅斑狼瘡活動期,抗Sm抗體檢測均可顯示出陽性,故可作為系統性紅斑狼瘡的標誌性抗體。但紅斑狼瘡患者中抗Sm抗體陽性者僅占30%左右(20%~30%),故抗Sm抗體陰性時也不能排除系統性紅斑狼瘡診斷,要結合其他檢查,符合診斷標準才能診斷。
正常值參考範圍
正常人抗Sm抗體均為陰性。
注意事項
抗Sm抗體是診斷系統性紅斑狼瘡的“標記”,雖然有時其抗體滴度與疾病活動度有關但決非制定治療方案的依據和判斷療效的指標。對單有自身抗體陽性而無明顯臟器損害者要慎重選擇激素治療,或在一定條件下並不需要激素治療,只需積極隨訪觀察。